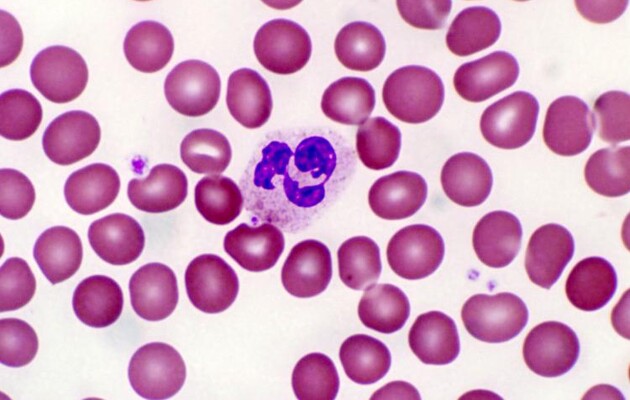
Відкрито нейтрофіли, які можуть допомогти в боротьбі з деменцією

Вчені з США виявили новий вид паличкоядерних нейтрофілів серед імунних клітин ссавців. Ці клітини показали в лабораторних умовах здатність зупиняти відмирання нервових клітин і навіть відновлювати зв'язки між ними, повідомляє Naked science.
У своїй статті вчені вивчили властивості клітин як в пробірці, так і в організмі лабораторних мишей. Вчені з'ясували, що ці клітини виробляють специфічні фактори росту. На них активно реагують нейрони, які отримали серйозні пошкодження. В результаті активності щойновідкритих нейтрофілів нервові волокна починають відновлюватися й рости знову. Таким чином тканини центральної нервової системи не тільки знижують шкоду від отриманих травм, а й можуть компенсувати її.
Відзначається, що відкриття вчених має дуже багатообіцяючі наслідки, незважаючи на те, що ці клітини знаходяться на дуже ранньому етапі дослідження. Зрозумівши механізм роботи таких імунних клітин, вчені зможуть спробувати зімітувати їхню роботу. Потенційно, відкриття може стати важливим кроком на шляху боротьби з нейродегенеративними захворюваннями.
У лабораторних умовах відкриті вченими імунні клітини допомогли відновити зоровий нерв і спинний мозок. У наступній роботі дослідники хочуть перевірити роботу нейтрофілів на людських тканинах.
Вчені вважають, що їхнє відкриття може допомогти в боротьбі не тільки з хворобою Альцгеймера, але і іншим захворюваннями, такими як розсіяний склероз і бічний аміотрофічний склероз.
Підписуйтесь на наш Telegram-канал з новинами технологій і культури.
Раніше вчені з Університету Пенсільванії вивчили тканини мозку померлого донора і знайшли в них ознаки нового нейродегенератівного захворювання. Хворобу викликає рідкісна генетична мутація, а за ознаками вона схожа на хворобу Альцгеймера.